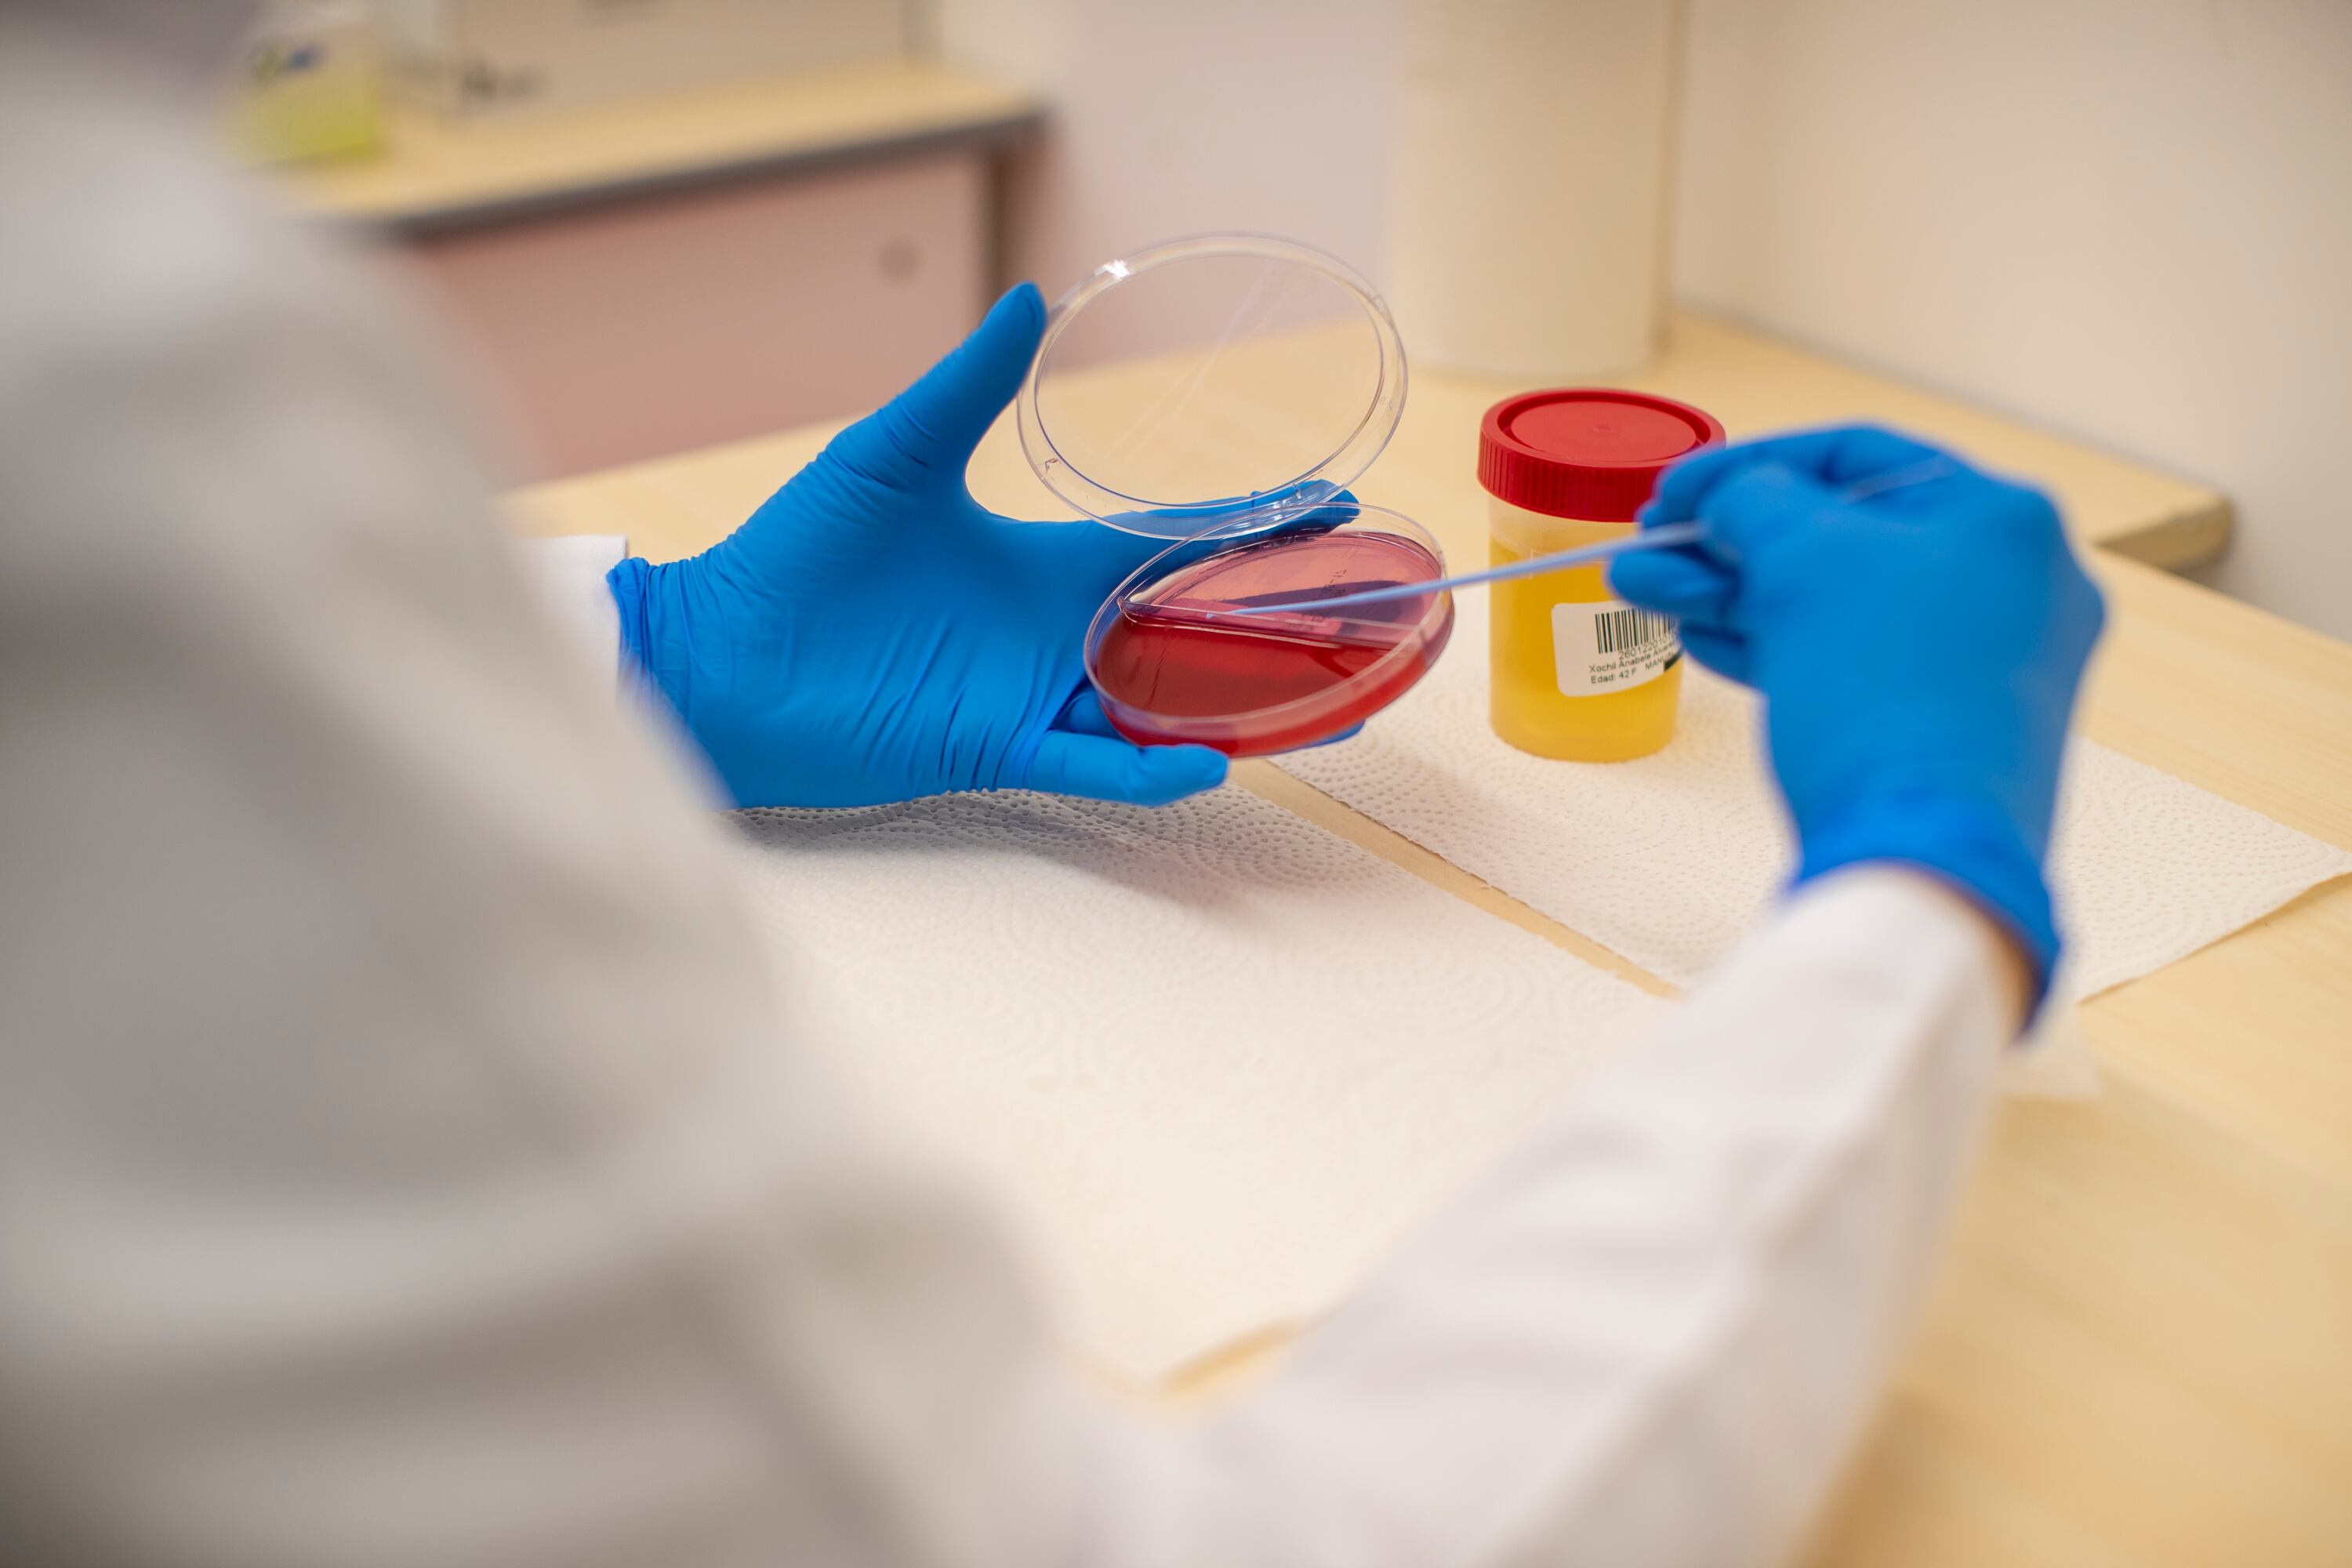

Una proteína podría ser la respuesta para tratar el síndrome respiratorio severo que sufren algunos pacientes que presentan complicaciones por covid-19. Esta posibilidad podría resultar en la primera patente de invención que logre la Caja Costarricense de Seguro Social (CCSS).
Esta es una hipótesis desarrollada por el presidente ejecutivo de la institución Román Macaya Hayes. El estudio está en fase preclínica, es decir, aún no ha llegado a seres humanos. Sin embargo, Macaya ya presentó una solicitud de patente ante la Oficina de Patentes y Marcas de Estados Unidos para que, de resultar exitosa, esta quede en manos de la CCSS, lo que permitirá obtener beneficios económicos.
¿En qué consiste esta proteína? Su nombre es Klotho, fue descubierta en 1997. y en el pasado se le han conferido propiedades antienvejecimiento. Estas proteínas son secretadas por los riñones y de allí se distribuyen a todo el cuerpo.
La hipótesis de Macaya, quien trabaja este proyecto con la doctora Natalia Campos Obando, es que Klotho puede proteger al cuerpo de las manifestaciones graves que ocasiona el coronavirus. La esperanza es que se desarrolle un tratamiento. Si esto es así, la CCSS tendría la patente y le permitiría tener ganancias en el caso de que otros laboratorios la desarrollen.
“El estudio busca contestar una respuesta muy sencilla pero que hoy no tiene respuesta: ¿cómo es que un virus tan sencillo como el SARS-CoV-2 puede desencadenar una enfermedad severa de tantos diferentes factores de riesgo (...) y cómo es que ese mismo virus también puede generar tantas manifestaciones diferentes de la enfermedad, desde asintomáticos hasta personas que fallecen, y, en medio de eso, una gran variedad e intensidad de síntomas”, planteó Macaya la mañana de este miércoles, en conferencia de prensa.
De acuerdo con el jerarca, para que una patente se apruebe debe cumplir con tres requisitos:
- Que sea novedosa, que nadie haya descrito esto antes.
- Que la solución propuesta no sea obvia.
- Que haya una utilidad para las personas o para el mejoramiento de la sociedad.
“Con esto comenzaría a generarse propiedad intelectual de la institución y sería un paso previo a poder generar monetización a través del conocimiento científico”, añadió.
LEA MÁS: Junta Directiva de la CCSS aprueba nuevo reglamento para investigar con pacientes de hospitales
LEA MÁS: CCSS se abre a la posibilidad de hacer investigación clínica con farmacéuticas
Si la sustancia pasa las fases preclínicas en laboratorio y es candidata a utilizarse en un protocolo en seres humanos, esa segunda fase se realizaría bajo rigurosos esquemas de consentimiento informado y de seguimiento a cada uno de los participantes.
Juan Carlos Esquivel, director del Centro de Desarrollo Estratégico e Información en Salud y Seguridad Social (Cendeisss), ente encargado de coordinar y regular la investigación en la CCSS recalcó que, en esta y otras investigaciones, la participación de las personas es completamente voluntaria. Cada participante, además, será informado sobre los distintos pasos del protocolo.
“Se protege la dignidad del paciente en todo momento. Si un paciente desea ser parte del protocolo lo va a consentir y tendrá el derecho de estar informado en todo momento de cualquier derecho. El consentimiento informado es esencial. Ningún paciente va a ser forzado a ser parte de una investigación”, recalcó Esquivel.
Todo el proceso se hará de acuerdo con la Ley de Investigación Biomédica, su reglamento y las normativas internas de la CCSS, además de los marcos internacionales.
LEA MÁS: Estudio de anticuerpos de covid-19 en ticos se amplía para explorar más a fondo la enfermedad
Oportunidad
La búsqueda de una fuente de ingresos a través de la investigación es muy importante para la institución en momentos en que la transición demográfica hace que sean cada vez menos las personas que aportan dinero para el sostenimiento de los servicios de salud y que, además, cada vez más individuos requieren de una pensión y de los servicios hospitalarios, que también tienen un alto costo.
La esperanza es que esta posibilidad de ofrecer tratamientos se dé con otras enfermedades y condiciones de salud, lo cual no solo beneficiaría de forma monetaria, sino también la calidad de vida de las personas que sufren los padecimientos.
“Hay enfermedades que hoy por hoy llegan hasta un punto donde la medicina actual ya no tiene más que ofrecer. Ahí es donde entran los protocolos de investigación. Eso abre posibilidades de opciones que puede conversar con su familia para tener esa opción que puedan ayudarle a mitigar su enfermedad y mejorar su salud”, expresó el jerarca.
La CCSS participará de estudios en los que también se colabore con otras instituciones, tal es el caso de ensayos que se hacen en conjunto con la Agencia Costarricense de Investigaciones Biomédicas (ACIB), que buscan determinar si una dosis de la vacuna contra el papiloma humano (VPH) es suficiente para proteger contra el cáncer de cérvix. Actualmente, se utilizan dos dosis, pero de comprobarse que una dosis basta, esto ayudaría a los diferentes sistemas de salud pública del mundo.
También se desarrollan estudios para ver la cantidad de anticuerpos que los costarricenses han generado contra el virus SARS-CoV-2 y sobre la concentración de virus que hay en el aire en los centros de salud de la CCSS.
A esto se le añade la segunda fase de investigación de suero equino como tratamiento contra covid-19, la cual comenzó en febrero de 2021 luego de ajustar aspectos vistos en los resultados de la primera fase hecha en 2020. Este programa se hace en conjunto con la Universidad de Costa Rica (UCR).
El Cendeisss también analiza la creación de un biobanco, un proyecto que consiste en muestras biológicas donadas de pacientes para hacer futuras investigaciones. Las personas brindan su consentimiento para dar sus tejidos y se garantizará la privacidad de los datos.
LEA MÁS: 3.000 ticos participarán en estudio sobre inmunidad contra covid-19
Garantizar recursos
Para investigar se necesitan dos aspectos fundamentales: dinero para hacerlo y que los investigadores tengan el conocimiento, pero además, el tiempo para dedicar a sus pesquisas.
Con ese objetivo se han aumentado la cantidad de cursos de buenas prácticas de investigación clínica y se buscarán incentivos para que las personas tengan tiempo para destinar a sus proyectos de investigación cuando ya las propuestas estén presentadas. Según el caso, se verá si este permiso temporal durante el estudio será exclusivo o combinado con otras actividades.
El acceso a financiamiento dependerá de si esta es en colaboración con otras instituciones que también aportan dinero o si es exclusiva de la Caja. La institución tiene el Fondo estratégico de desarrollo de investigación e innovación (FEDII), que subirá su tope de ¢800 millones a ¢3.000 millones para 2023. Esto dependerá de lo que cada investigación requiera y también podría financiar patentes y trámites de patentes.
LEA MÁS: País frena su participación en ensayos de curas para coronavirus
